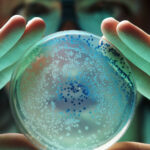

Quest Diagnostics has signed up to offer a blood test that can help diagnose Alzheimer’s disease, following its FDA clearance earlier this year.
Developed by Fujirebio, the Lumipulse G test measures the ratio between specific tau and beta amyloid proteins found in the bloodstream to identify patients likely to have plaque buildups in the brain without requiring them to undergo brain scans or spinal tap procedures.
The in vitro kit claimed the agency’s first 510(k) green light in the field this past May. A previous version of the Lumipulse G diagnostic received a de novo clearance for testing samples of cerebrospinal fluid.
Related
Other diagnostics companies, including Quest, Labcorp and more, have offered blood-based assays for a variety of tau and amyloid biomarkers linked to Alzheimer’s, but as lab-developed tests without FDA clearance. Quest said the addition of Lumipulse G to its catalog will complement its current AD-Detect product line.
“Our goal is to advance access to quality and innovative blood-based tests for Alzheimer’s disease. Adding the Fujirebio test to our existing blood-based tests provides the many physicians we serve with another powerful option for assessing patients for Alzheimer’s disease,” Kathleen Valentine, the general manager of Quest’s neurology business, said in a statement.
Quest estimates that nearly 7 million people in the U.S. have Alzheimer’s, with projections reaching 14 million by 2060. At the same time, about 12% to 18% of people over the age of 60 have the early stages of mild cognitive impairment.
Related
And with the advent of newly approved therapies for reducing amyloid levels—including the FDA’s green light earlier this week for a new dosing regimen of Eli Lilly’s Kisunla antibody—a faster path to a diagnosis will be key to increasing the accessibility of those treatments.
“Blood-based testing can be less invasive and more convenient than traditional test methods,” Valentine said. “We are excited to leverage our expansive network of patient service centers to broaden access to the Fujirebio innovation to help more at-risk individuals gain access to the insights they need sooner.”
Quest said it plans to make the Lumipulse G test available to clinicians and biopharma companies later this summer. The company, along with Fujirebio, also plans to highlight their neurological tests at the Alzheimer’s Association International Conference, being held in Toronto later this month.